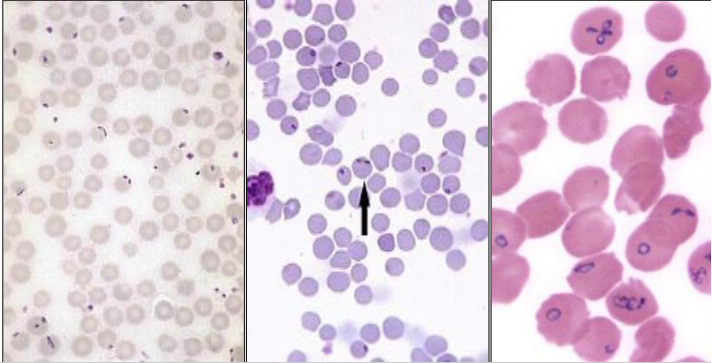
<p>Why did this animal succumb to babesia divergens and not others that were reared on the same farm?</p>
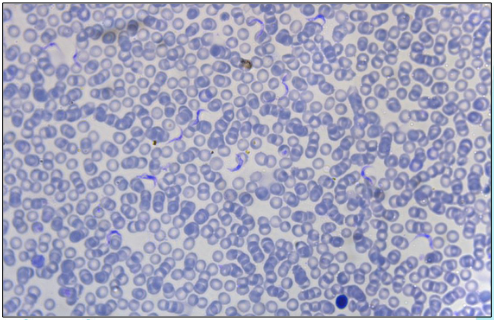
<p>A blood smear from a cow in Tanzania that is weak, emaciated, and no longer gives milk.</p><p>Name the parasite </p>
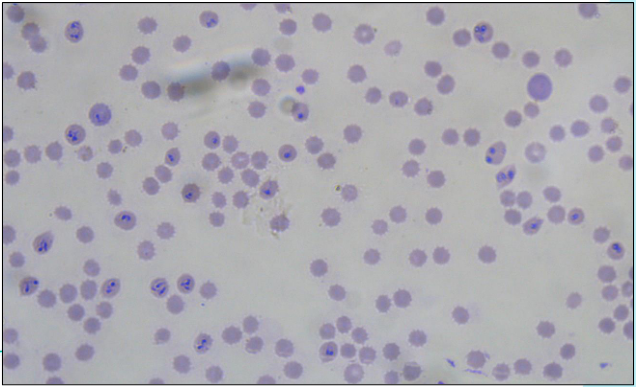
<p>A blood smear from a dog returning to the UK after a summer holiday in the south of France, having collapsed 2 weeks later with acute anaemia.</p><p>What is the parasite?</p>

1/31
Looks like no tags are added yet.
Name | Mastery | Learn | Test | Matching | Spaced | Call with Kai |
|---|
No study sessions yet.

What can be seen within the red blood corpuscles?
abnormal inclusions

This blood smear was taken from a replacement dairy heifer that was bought onto a farm with lots of rough grazing. Signs included anaemia, haemoglobinuria, fever and lethargy.
Identify the parasite.
babesia divergens
Why did this animal succumb to babesia divergens and not others that were reared on the same farm?
it did not have immunity
animals on the farm were likely to have immunity as a result of exposure to infection early in life while partially protected by maternal antibodies

What cows are at higher risk of disease from babesia divergens?
immunologically naiive hosts brought into endemic areas

A client who raises laying hens on straw bedding sends you this photograph of the caeca of a bird that was found dead.
Which parasite is likely to have caused this?
coccidiosis (in particular a species of EImeria that infects the caeca, such as E. tenella)

Name 2 factors that straw bedding provides, which are conducive to infection with this parasite
intact faeco-oral cycle
high moisture and temperature suitable for development to the infective stage

Structures observed under high power magnification of a preparation in the faeces of a rabbit showing lethargy, dehydration and diarrhoea.
Name the parasite
Eimeria sp. or coccidiosis

What does Eimeria stiedae cause in rabbits?
hepatic coccidiosis

What causes hepatic coccidiosis in rabbits?
Eimeria stiedae

Is it easy to distinguish different species of Eimeria?
NO

Name the life cycle stage
oocyst

How long can the oocyst (as shown in the image) survive in the environment in optimal conditions (1 week/1 month/1 year)?
a year or more

What is survival of an oocyst reduced by?
desiccation
high temperature
e.g. in compost or by disinfection

What kind of animal is this?
tick

Name protozoal diseases that ticks carry
babesia canis
babesia divergens

What does this image show?
life cycle of the coccidian parasite (Eimeria sp.)

Name the lifecycle stage labelled 1
schizogony or merogony

Name the lifecycle stage labelled 2
gametogony

Name the life cycle stage labelled 3
sporulation
A blood smear from a cow in Tanzania that is weak, emaciated, and no longer gives milk.
Name the parasite
Trypanosoma brucei

A blood smear from a cow in Tanzania that is weak, emaciated, and no longer gives milk.
What sickness does Trypanosoma brucei cause in humans?
sleeping sickness, or human African trypanosomiasis (HAT)

A photomicrograph of a cystic structure found during histological examination of a mouse’s brain, as part of a research project investigating parasite-induced modification of animal behaviour.
Name the parasite
toxoplasma gondii

What are the consequences of infection with toxoplasma gondii in an adult cat?
none or minimal
possible some transient diarrhoea
kittens can be infected in utero and be born weak

What are the consequences of infection with Toxoplasma gondii in a pregnant sheep?
abortion
stillbirth
apparently barren

What are the consequences of infection with toxoplasma gondii on a pregnant human?
possible miscarriage
a child infected in utero can develop retinal lesions and vision loss

What are the consequences of infection with toxoplasma gondii in a healthy, non-pregnant, immunocompetent person?
none or minimal
flu-like sings
bradyzoite cysts can establish in the brain but are unlikely to lead to clinical disease, though could affect behaviour

What are the consequences of infection with Toxoplasma gondii in a person suffering from AIDS?
generalised, tachyzoite infection that can be fatal

A photomicrograph of a protozoal parasite associated with diarrhoea in dogs. Name the parasite
Giardia

Can Giardia be zoonotic?
in principle YES
in practice, most strains seem to circulate separately in dogs & humans
probably more human-to-dog than dog-to-human transmission
A blood smear from a dog returning to the UK after a summer holiday in the south of France, having collapsed 2 weeks later with acute anaemia.
What is the parasite?
Babesia canis

What protozoal parasite is transmitted by this insect?
Leishmania

What is this insect?
sandfly